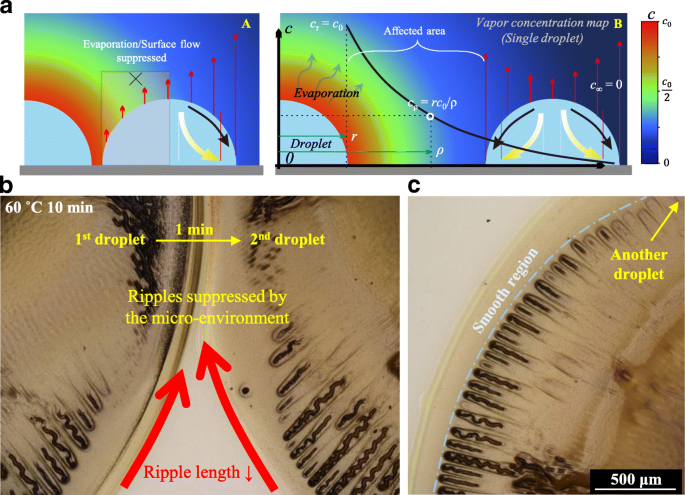
Controlling Zigzag Hollow Cracks in Silver Nanoparticle Films via Drying Micro‑Environment Regulation

Controlling Zigzag Hollow Cracks in Silver Nanoparticle Films via Drying Micro‑Environment Regulation
Abstract
We demonstrate that evaporation dynamics are the decisive factor in forming zigzag hollow cracks in silver nanoparticle films. By tailoring the drying micro‑environment—specifically the spatial distribution of vapor flux and solvent evaporation rate—we can manipulate surface flows and suppress the compressive stresses that drive crack nucleation. Our results show that a more uniform evaporation profile yields a smoother, defect‑free surface, providing a practical framework for optimizing solution‑processed metal films for high‑performance electronic and optical applications.
Introduction
Silver, gold, and copper precursor inks are attractive for flexible electronics because they can be processed below 200 °C, yet cracking remains a major obstacle that degrades conductivity and adhesion [1][2]. While previous work has focused on external stimuli such as laser or pulsed light, the intrinsic role of uneven evaporation—known to produce the coffee‑ring effect—has been underappreciated [6]. Rapid solvent loss at droplet edges creates outward Marangoni flows that drive nanoparticles toward the periphery, building up compressive stress and leading to zigzag hollow cracks.
In this study we enhance the coffee‑ring effect through ink formulation, enabling controlled self‑assembly of nanoparticles at the droplet rim. We then investigate how the drying micro‑environment, particularly vapor concentration gradients and inter‑droplet spacing, governs the evolution of surface cracks. By isolating evaporation from other variables, we reveal a clear causal link between solvent dynamics and crack formation, and we propose practical strategies to suppress defects during solution‑based film deposition.
Materials and Methods
Silver acetate (2.5 g), ethyl alcohol (EA, 3 ml) and octylamine (OA, 3 ml) were mixed under magnetic stirring at room temperature for 2 h. The ink was filtered through a 0.22 µm membrane prior to use. Glass slides were sequentially cleaned with deionized water, isopropyl alcohol and tetrahydrofuran in an ultrasonic bath for 10 min each. Droplets of ~5 mm diameter were deposited with a 0.25 mm‑diameter syringe nozzle (Fig. 1a). Larger droplets provide a longer drying time proportional to r², facilitating observation of crack development.
Films were cured using either a hotplate or a 600 W UV source (IntelliRay, Uvitron, USA). The UV unit was equipped with a hydrophilic‑blocking filter. Optical microscopy (Nikon Eclipse E600 POL, 1000×) and SEM (NOVA NANOSEM 430) with an EDS module were employed to characterize surface morphology and elemental composition.

Crack formation process. a Droplet released by a syringe. b Schematic of the induced directional flows. c, d, e The released droplets followed by cycles of UV irradiation. f Schematic of different morphologies for different regions
Results and Discussion
The coffee‑ring effect and the accompanying Marangoni flow are illustrated in Fig. 1b. OA/EA ratio rises at the droplet edge because OA has a higher boiling point (176 °C) and surface tension (28 dyn/cm) than EA (78 °C, 22 dyn/cm), which establishes an outward surface flow. After two UV cycles (60 s each) three distinct regions emerge (Fig. 1c). Region I collects solutes quickly and solidifies into a smooth rim; Regions II and III retain a nanoparticle suspension, with Region III becoming sparser. Increasing UV cycles transforms Region III from ripples (3 cycles) to pronounced cracks (10 cycles), while Region II remains rough and Region I stays defect‑free (Fig. 1d,e). These observations confirm that compressive stress, amplified by evaporation‑driven flows, dictates crack nucleation.
Solution‑processed films cured with UV exhibit a milder coffee‑ring effect compared to thermal curing [8], as evidenced by smoother surfaces in Fig. 2a. Continuous UV exposure for 5 min, however, introduces zigzag ripples at the periphery (Fig. 2b). These ripples arise from increased radial compressive stress caused by enhanced outward flow and evaporation gradients. Moderate substrate heating (60 °C) produces more regular zigzag patterns, and the ripples persist regardless of sintering time (5–15 min) (Fig. 2c). As the film solidifies, compressive stress induces cracks along these ripples (Fig. 2d). Post‑drying, a hollow interior within the ripples is revealed by SEM–EDS mapping of silver.

Zigzag hollow cracks. a Schematic of the difference between UV irradiation and thermal treatment for the forming of surface nanoparticle film. b Zigzag-shaped ripples obtained with UV irradiation for 5 min. c More regular ripples obtained at a heated glass substrate at 60 °C for 5 to 15 min. d SEM-EDS measurements
By modeling solvent evaporation as a simple vapor diffusion process (cρ = r c₀/ρ), we generated a color map of vapor concentration (Fig. 3a). When two droplets are deposited in close proximity, asymmetric evaporation fluxes emerge (Fig. 3b). The reduced evaporation rate and suppressed surface flow at short inter‑droplet distances suppress ripple formation, producing smoother peripheries. As the spacing increases, the outward flow strengthens, raising inter‑droplet pressure and restoring zigzag ripples (Fig. 3c). The first droplet, deposited 60 s before the second, experiences less evaporation influence, further mitigating crack formation in subsequent droplets.
Zigzag hollow cracks regulated by its drying micro-environment. a Color map of the drying micro-environment based on the simplest vapor diffusion model. b Effect of the drying micro-environment on two subsequently released droplets with a short distance. c Ripples change from the nearest region to the farther region of two neighboring droplets
These findings not only offer a concrete method to suppress zigzag hollow cracks but also validate the intrinsic link between solvent evaporation and crack nucleation. Practical mitigation strategies include (i) accelerating chemical reduction to increase solute concentration before film formation, and (ii) reducing droplet size via inkjet printing. Inkjet‑printed films (≈50 µm droplets) form dense, crack‑free surfaces even when cured at 100 °C for 30 min, benefiting from faster solidification, lower local evaporation, reduced fluid flow, higher solute concentration, and a modified drying micro‑environment.
Conclusion
We have established that evaporation dynamics are the principal driver of zigzag hollow crack formation in solution‑processed silver nanoparticle films. By manipulating the drying micro‑environment—through controlled evaporation gradients, inter‑droplet spacing, chemical reduction rate, and droplet size—one can fine‑tune surface morphology and suppress defects. These insights provide a robust, scalable pathway to fabricate high‑quality, crack‑free nanoparticle films for advanced electronic and photonic devices.
Abbreviations
- DI:
Deionized
- EA:
Ethyl alcohol
- EDS:
Energy-dispersive X-ray spectrometer
- OA:
Octylamine
- SEM:
Scanning electron microscope
- UV:
Ultraviolet
Nanomaterials
- Fabricating Electrically Conductive Silica Nanofiber–Gold Nanoparticle Composites via Laser Pulses and Sputtering
- Boosting MgZnO MSM Photodetector Performance with Pt Nanoparticle-Driven Surface Plasmons
- Infrared Electromagnetic Field Redistribution on Graphene by Silver Nanoparticle Dimers
- High-Performance Recyclable Starch‑Ag Networks for Transparent Conductive Electrodes in Flexible Joint Sensors
- Time‑Resolved Corrosion Dynamics of Single‑Crystalline Silver Triangular Nanoparticles
- Sm-Doped CeO₂-δ Thin Films on Al₂O₃(0001): Superior Surface Proton Conduction
- Boosting ZnO UV Emission with Silver Nanoparticle Arrays via Surface Plasmon Resonance
- In‑Situ Synthesis of Silver Nanoparticles on Amino‑Grafted Polyacrylonitrile Fibers for Enhanced Antibacterial Performance
- Understanding Carbon Film Resistors: Basics, Types, and Applications
- OSP: The Reliable, Cost-Effective Surface Finish for Copper PCBs